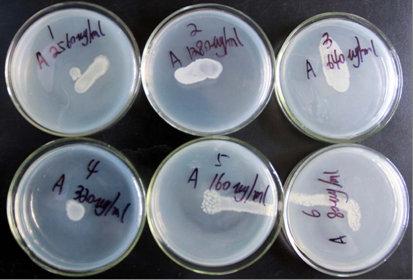
快速硫化氢试验琼脂

快速硫化氢试验琼脂
H2S Test Medium
询价
20g
起订
上海 更新日期:2026-04-21
产品详情:
- 中文名称:
- 快速硫化氢试验琼脂
- 英文名称:
- H2S Test Medium
- 产品类别:
- 培养基
- 名称:
- 快速硫化氢试验琼脂
公司简介
上海纪宁实业有限公司致力于酶联免疫ELISA试剂盒、生物科研试剂、国家标准物质、水质检测产品、环境污染检测研发生产,是一家集研发、生产、销售相关试剂及仪器的企业,科研实验、为环境检测、水产养殖、消毒残留、以及工业排放等行业提供优质、简单、快捷的自测产品。我们一直处于中国生物科技行业领先地位,我们的宗旨是为客户提供最高效、最快速、最实惠、最方便的检测服务!
| 成立日期 | (14年) |
| 注册资本 | 10万人民币 |
| 员工人数 | 1-10人 |
| 年营业额 | ¥ 300万-500万 |
| 经营模式 | |
| 主营行业 |
快速硫化氢试验琼脂相关厂家报价 更多
-

- 快速硫化氢试验琼脂
- 青岛高科技工业园海博生物技术有限公司
- 2026-04-21
- ¥95
-

- 快速硫化氢试验琼脂
- 上海沪震实业有限公司
- 2026-04-21
- 询价
-

- 快速 三烯丙基异氰酸酯 1025-15-6 粘合剂改性剂 快速
- 武汉吉业升化工有限公司 VIP
- 2026-04-22
- ¥36
-

- 药敏试验琼脂培养基基础
- 上海冠导生物工程有限公司 VIP
- 2026-04-22
- 询价
-

- 含甲基绿的DNA酶试验琼脂培养基基础
- 上海宾穗生物科技有限公司 VIP
- 2026-04-22
- ¥612